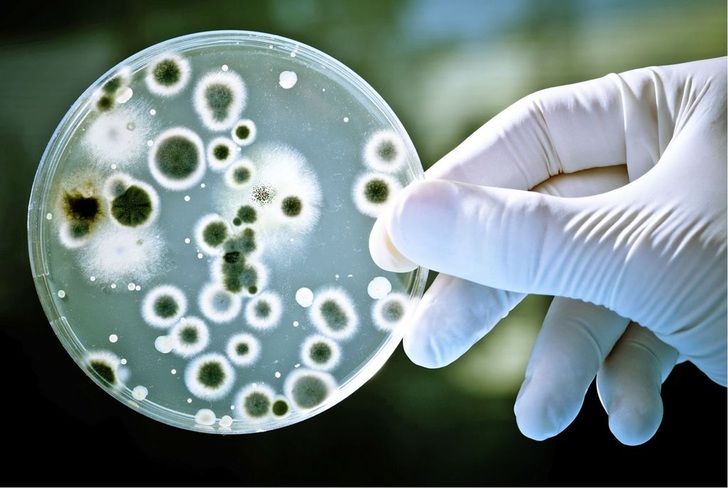

Zur Lufterneuerung, zur Beseitigung des Kochwrasens und zur Fettabscheidung sind in gewerblichen Küchen hochwirksame Lüftungsanlagen unverzichtbar. Hauptsächlichaus hygienischen Gründen favorisieren die Großküchenplaner Metalldecken, die sich fugenlos von Wand zu Wand schwingen und deren glatte Oberflächen sich mit dem Dampfstrahler reinigen lassen. Es gibt aber noch einen ganz praktischen Aspekt für die wachsende Beliebtheit der Deckenlösung: Die Fettabscheider sind nicht wie bei der Dunstabzugshaube örtlich fixiert; sie lassensich nachträglich versetzen, wenn der Herdblock erweitert oder anderswo platziert wird. Die bisherigen Öffnungen werden dann durch Blindstücke verblendet. Die genannten Vorzüge lassen die Großküchenplaner vermehrt zur Deckenlösung greifen. Sie ist Bestandteil der DIN 18869 Einrichtungen zur Be- und Entlüftung von gewerblichen Küchen, die in erster Linie den Arbeitsschutz und die Hygiene im Visier hat. Auch die neue Euronorm EN 16282 beruht im Wesentlichen auf der DIN 18869.
Alles dicht
Moderne Lüftungsdecken für Großküchensind in Flachbauweise konstruiert. Als Werkstoff dient Edelstahl oder eloxiertes Aluminium, auf Wunsch pulverbeschichtet im gewünschten RAL-Farbton. Die nicht aktivenZonen bestehen aus schalldämmenden Paneelen oder Kassetten. Diese sind mit Dämmstoff hinterlegt, der wasserdampfdicht in Folie eingeschweißt ist. Die Abluftelemente sind in Form von Lüftungsbalken abgehängt. Darin befinden sich die Absaugöffnungen mit den versetzbaren Fettabscheidern. Die Zuluft, sofern nicht durch eine separate Lüftungsanlage eingebracht, verlässt die Lüftungsbalken durch Schlitzdurchlässe. Bündig auf der Unterseite eingesetzt sind normalerweise auch die Beleuchtungsbänder.
Abluftbalken und Abluftraum bilden eine geschlossene, kondensatdichte Konstruktion. Die Abluft strömt somit kontrolliert in die Luftkanäle und kommt nirgendwo mit dem Bauwerk in Berührung. Das erspart dem Bauherrn die periodische Reinigung des Deckenhohlraumes und beugt der Versottung des Mauerwerkes durch Fettsäure vor. Zudem wird auch der vorbeugende Brandschutz verbessert. Die Abluftsegmente werden weitgehend in der Werkstatt vorgefertigt und auf Dichtheit geprüft. Das verkürzt die Montagezeit auf der Baustelle und lässt auch die zügige Modernisierung zu, ohne den Küchenbetrieb nennenswert einzuschränken.
Die Alternative zu den geschlossenen Deckenkonstruktionen sind die offenen Varianten. Sie sind preiswerter, weil der vorhandene Deckenhohlraum als Abluftkammer dient. Allerdings ist hier eine Versiegelung der Zwischendecke unverzichtbar. Eine Reinigung des Deckenhohlraumes ist regelmäßig durchzuführen. Denn alles, was an Feuchtigkeit und Fettresten in die Abluft gelangt, verunreinigt auch die Zwischendecke.
Hochwirksame Fettabscheider
Die Fettabscheider in den Abluftöffnungen haben die herkömmlichen Gestrickfilter verdrängt. Letztere findet man nur noch in Dunstabzugshauben, obwohl sie nicht mehr dem Stand der Technik entsprechen. Der gravierende Unterschied zwischen Filter und Abscheider: Der Abscheider speichert nicht das Fett in einem Metallgestrick, sondern schleudert es durch die Luftablenkung aus und leitet es in eine Fettsammelrinne ab. Laut VDI-Richtlinie 2052 (Raumlufttechnische Anlagen für Küchen) müssen Aerosolabscheider aus Chromnickelstahl bestehen; Aluminium-Gestrickfilter sind somit nicht mehr zulässig. Es gibt noch einen weiteren Unterschied: Fettfilter sind nicht flammendurchschlagsicher. Sie können bei unzureichender Wartung einen Luftkanalbrand verursachen. Moderne Fettabscheider, als Zyklon-Abscheider mit mehrfacher Luftumlenkung konstruiert, dienen dagegen als Flammensperre, sofern sie der Bauart A gemäß DIN 18869-5 entsprechen. Bei der Auswahl sollte der Planer auf diese Eigenschaft achten. Macht er das nicht, entsteht im Schadensfall schnell die Frage nach der Mithaftung.
Auch flammhemmende Abscheider entsprechen nicht der Norm und somit nicht dem Stand der Technik. Die Flammendurchschlagsicherheit wird durch ein DIN-Prüfsiegel dokumentiert (siehe Kasten).Hochwirksame Fettabscheider gehören pe-riodisch, in der Regel wöchentlich, in die Geschirrspülmaschine. Dieser Aufwand lässt sich jedoch auf eine jährliche Prüfung reduzieren, wenn die Decke mit einer Waschautomatik ausgerüstet ist. Einige Deckenanbieter offerieren dieses Zubehör, das reduziert die Verfettung des Abluftkanales und somit die Brandgefahr.
Fragwürdige Gutachten
Anbieter von Küchendecken werben nicht selten mit Hygienegutachten, um die Überlegenheit ihrer Aerosolabscheider und Waschanlagen herauszustellen. Diese Gutachten sind oft fragwürdig, denn sie stützen sich meist auf Messungen in relativ keimfreien Küchen von Krankenhäusern und Altenheimen. Hier ist die Keimbelastung von vornherein geringer als in Gastroküchen und Grillstuben, wo viel fettreicher gekocht wird. Entsprechende Gutachten täuschen also den Kunden.
Hygienegutachten sind laut Reven nur dann seriös, wenn das Prüfinstitut die Lüftungsanlage mit verschiedenen Bakterienstämmen, wie sie in gewerblichen Küchen vorkommen, impfen und danach die Effizienz der Abscheider messen. Waschanlagen müssen darüber hinaus in der Lage sein, Bakterien abzutöten und deren Wachstum zu verhindern. Der Nachweis gelingt jedoch nur, wenn vor dem Test entsprechende Keime auf den Abscheideelementen sowie im Ansaug- und Abluftbereich ausgesetzt werden. Ohne diese Maßnahme sind die Messungen wertlos.
Induktionsdecke spart Energie
Eine besonders energiesparende Deckenvariante ist die Induktionsdecke. Dabei strömt ein Teil der Zuluft in der Deckenzone direkt zur gegenüberliegenden Absaugstelle und zieht von unten den Kochwrasen an. Dieser Zuluft-Anteil hat also nur eine Schleppfunktion und gelangt nicht in den Aufenthaltsbereich der Köche. Er muss demnach nicht vorgewärmt werden.
Anders bei der konventionellen Lüftung: Hier durchflutet der volle Außenluftstrom die Küche und ist laut VDI-Richtlinie 2052 auf mindestens 19 °C vorzuwärmen. Das verursacht beträchtliche Energiekosten von der Zugerscheinung abgesehen. Beim Induktionsprinzip ist demnach nur die Außenluftmenge aufzuwärmen, die zur Lufterneuerung der Küche notwendig ist. Das sind 30 bis 50 Prozent der Zuluftmenge. Entsprechend gering ist auch der Energieeinsatz. Rentschler Reven wendet das patentierte Induktionsprinzip sowohl für Dunstabzugshauben als auch für Lüftungsdecken an. Die Mehrkosten gegenüber der herkömmlichen Technik zwischen 30 und 40 Prozent sollen sich binnen 1,5 bis 2 Jahren amortisieren.
Keine Gerüche
Feuerlöschautomatik, Luftmengenregelung und vor allem Geruchsfilter ergänzen die Zubehörliste einer modernen Lüftungsdecke. Viele Anbieter setzen noch Aktivkohle zur Geruchsneutralisation der Fortluft ein obwohl alle Fachleute wissen, dass Aktivkohle für Küchenabluft gar nicht geeignet ist. Aktivkohle ist nämlich entzündlich und nur für eine maximale Umgebungstemperatur von 40 °C einsetzbar. Sie ist nicht keimtötend oder wachstumshemmend gegen Bakterien, verklebt ab 60 Prozent relativer Feuchte und ist als Sondermüll zu entsorgen.
Bewährt hat sich für die Geruchsneutralisation dagegen ein Granulatgemisch aus Vulkangestein und Kaliumpermanganat. Es ist unbrennbar, keimtötend und funktioniert bis zu 99 Prozent r. F. einwandfrei. Nach Ablauf der Standzeit wird das Granulat mit dem Hausmüll entsorgt.
Für die Geruchsneutralisation werden ferner UV-Röhren angeboten, die Geruchsmoleküle durch Ozonerzeugung kalt verbrennen. Das Verfahren funktioniert nachweislich, allerdings ist bei der Auswahl der UV-Röhren eine hohe Sorgfalt geboten, denn es gibt große Unterschiede hinsichtlich ihrer Lebensdauer und Leistungsfähigkeit. Einige Hersteller beziehen sich bei der Angabe der Lebensdauer auf eine Wellenlänge von 254 nm. Diese Strahlung erzeugt aber kein Ozon! Diese Wellenlänge wird vielmehr bei UV-C Anlagen in der Medizintechnik zum Keimtötung eingesetzt.
Eine wichtige Grundvoraussetzung für ein optimales Ergebnis mit UV-Röhren ist ferner eine effektive Vorabscheidung der Aerosole, weil sonst die Leuchten schnell verfetten und ihre Wirkung verlieren. PG -
Video zum Artikel
Webcode 1203
Kein Flammendurchschlag in den Abluftkanal
Spektakuläre Luftkanalbrände zwangen die Verantwortlichen zum Handeln: In gewerblichen Küchenmüssen die Fettabscheider über thermisch kritischen Geräten fortan auf Flammendurchschlag geprüft sein. Nicht nur über dem Herdblock, sondern auch im Garbereich. Das fordert die DIN 18869-5 und unterscheidet zwei Bauformen an Fettabscheidern: Bauart A (auf Flammendurchschlag geprüft) und Bauart B (nicht geprüft). Letztere taugen nur für die Speisenvorbereitung, das Speiselager und die Spülküche. Wie können Küchenplaner und SHK-Installateure, die beide mit in der Haftung sind, die DIN-Konformität erkennen? Sie sollten unbedingt auf das entsprechende DIN-Prüfsiegel achten. Fehlt das Prüfzeichen, ist der Fettabscheider allenfalls flammenhemmend und nicht auf Flammendurchschlag geprüft.